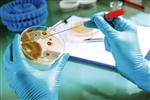

-
据外媒报道,德国慕尼黑工业大学凯撒·威廉物理化学和电化学研究所和于利希研究中心的科学家们组成的一个团队表示,在此类材料…[详细]
-
昆明理工大学化学工程学院磷化工团队基于先前的除甲醛涂料研究工作,提出将有机胺单体接枝到丙烯酸树脂上,制备了胺基改性水性…[详细]
-
1月30日,高性能防雾涂料领军企业FSI Coating Technologies, Inc.(FSICT)宣布推出Visgard® Premium SE(特别版)防雾涂料。[详细]
-
据外媒12月29日报道,苹果已申请了一项专利,保护项是其设备弯曲而不损坏的技术产品,与市场上的“弯曲”iPad pro无关,苹果的…[详细]
-
7月27日,江苏省科学技术厅公布了2018年度江苏省科学技术奖形式审查结果。其中,由中海油常州涂料化工研究院有限公司、中海油…[详细]
-
表明公司在该类项目上的研发投入已经逐步进入收获期。同时展现了公司该系列产品与国际大型公司的进口产品具备“同台竞技”的能…[详细]
-
3月26日,广东省科技创新大会在广州举行,大会颁发了2017年度广东省科学技术奖。涂界记者注意到,2017年度广东省科技奖共246项…[详细]
-
3月23日,科技部公布了2018年度国家自然科学奖、技术发明奖通用项目、科学技术进步奖通用项目受理项目目录。受理了国家自然科…[详细]
-
11月23日,在舟山500千伏联网工程现场,十余名工作人员正在为地面堆放整齐的一根根铁塔杆管喷刷“石墨烯改性重防腐涂料”,为…[详细]
-
PM2.5新克星在深圳横空出世!这款超能纳米涂层新材料能在8小时内有效降解 96.7%的PM2.5,同时大幅实现除醛灭菌。记者昨天在工…[详细]
-
记者从扬州大学获悉,扬州大学聚合物—无机微纳复合材料工程技术研究中心朱爱萍教授团队联合国内有关科研单位、企业,成功研制…[详细]
-
8月8日,佛山市科学技术局正式公布了2016年度佛山市科学技术奖项目名单(科技进步奖),其中华润涂料、美涂士、科顺防水、合众…[详细]
-
7月10日,据美国《大众机械》杂志网站报道称,英国和中国的科学家们合作研制出一种碳化锆(ZrC)制成的新型超高温陶瓷涂层,其…[详细]
-
7月18日,据俄罗斯航天国家公司网站报道称,俄罗斯航天系统公司(RKS)在MAKS-2017航展上展出了其开发的一种创新型电子设备辐…[详细]
-
涂界记者8月9日获悉,由中国建筑材料科学研究总院、北京大津硅藻新材料股份有限公司完成的“硅藻土基调湿净化功能材料研发及其…[详细]
-
涂界记者7月31日获悉,2017年浙江省科学技术奖入选项目进行了公示,其中由浙江大学、浙江顺虎德邦涂料有限公司完成的“高性能…[详细]
-
日前,科技部公布了 2017年度国家科学技术奖初评项目。涂界记者注意到,“海洋重防腐功能涂层材料关键技术研发与产业化应用”…[详细]
-
涂界记者7月17日获悉,北京中建柏利工程技术发展有限公司、中国建筑股份有限公司完成的“新型光触媒和节能降温水性功能涂料的…[详细]